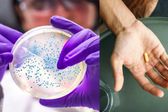
Advierten sobre una nueva emergencia de salud pública, este es el motivo

El día de hoy, miércoles 1 de enero, La Secretaría de Gestión Integral de Riesgos y Protección Civil de la Ciudad de México activó la Alerta Naranja.
Alcaldías que estarán afectadas por los fríos en Ciudad de México:
Álvaro Obregón, Cuajimalpa, Magdalena Contreras, Milpa Alta, Tlalpan y Xochimilco.
Se pronostican temperaturas de entre 1 y 3 grados Celsius entre las 00:00 y las 08:00 h del jueves 2 de enero de 2025.
La Alerta Amarilla fue anunciada también en las demarcaciones de Coyoacán, Miguel Hidalgo y Tláhuac.
Se prevén temperaturas de entre 4 y 6 grados Celsius, durante el mismo periodo de tiempo.
¿Cuáles son las recomendaciones?
Debido a las frías temperaturas, es probable que puedas contraer un resfriado por lo que te recomendamos usar al menos tres capas de ropa, de preferencia de algodón o lana.
No te olvides de utilizar crema para proteger e hidratar la piel contra el frío, evitar exponerse a cambios bruscos de temperatura, así como ingerir abundante agua; consumir frutas y verduras ricas en vitaminas A y C.
Lavarse las manos con frecuencia o usar gel antibacterial ayuda a que no te contagies alguna enfermedad.
En caso que presentes algún malestar, no dudes en acudir al centro de salud más cercano. Si usas calentadores y/o chimeneas, mantener una ventilación adecuada.
Ante cualquier emergencia, la dependencia capitalina pidió comunicarse a los teléfonos 911, al 5658 1111 de Locatel, y al 555683 2222 de Protección Civil de la Ciudad de México.

&format=webp)
&format=webp)